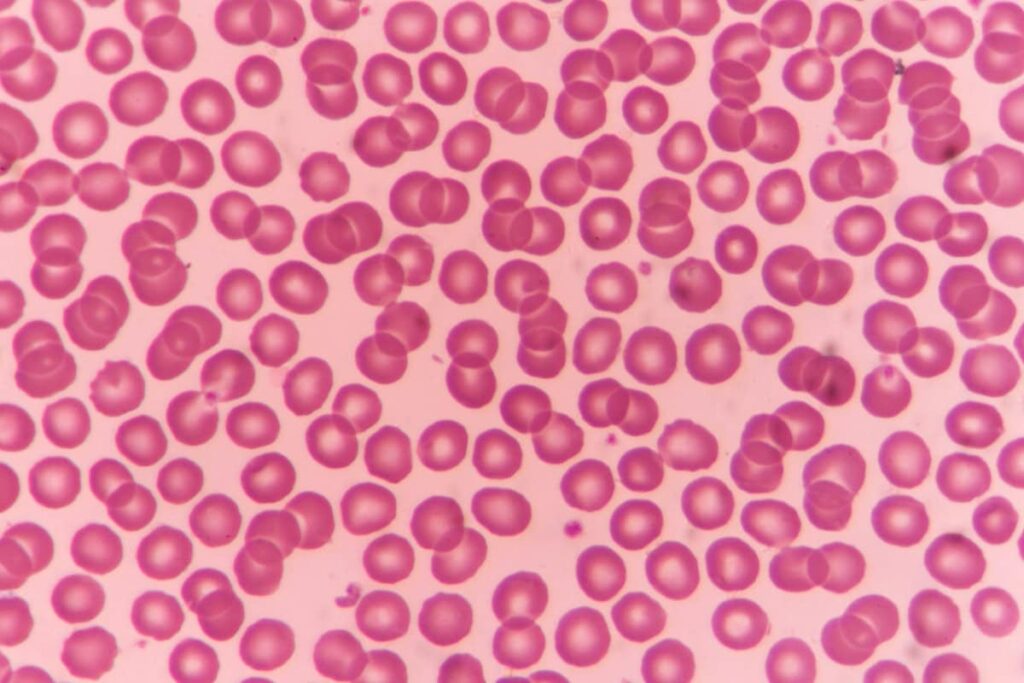
Microscopic red blood cells

The latest update to UK Biobank’s comprehensive dataset is now available to approved researchers around the world via UK Biobank’s Research Analysis Platform (UKB-RAP).
The new data have been added to the wealth of existing genetic, imaging, proteomic, lifestyle and health data, on our half a million generous volunteers. These data are being used by 22,000 researchers around the world to accelerate research in the public health interest.
This data release is one of our most significant updates yet, with metabolomic data, new imaging data, and more, adding to an already uniquely rich dataset. It’s going to be really exciting to see how researchers around the world use these data to make discoveries that would otherwise not be possible.
Professor Sir Rory Collins, Chief Executive and Principal Investigator, UK Biobank
This data release includes:
The world’s biggest dataset of metabolomics
Metabolomics is the study of the small molecules called metabolites that keep our bodies running, including sugars, fats and the building blocks of proteins called amino acids.
Investigating the levels of these molecules, combined with UK Biobank’s other data, should help researchers uncover new warning signs of disease, and provide a closer look at the biological pathways involved in disease. This, in turn, should result in better ways to predict and diagnose disease, and boost drug discovery.
Researchers have already had access to metabolomic data on 300,000 participants, and this data release brings the total to all half a million of UK Biobank’s volunteers, including 20,000 second samples taken 5 years after the first.
Metabolomic data on all half a million UK Biobank participants is a highly valuable resource, not just for disease prediction but also for understanding human health and aging.
Dr Najaf Amin, Associate Professor of Molecular Epidemiology, Oxford Population Health
Read the full press release below on why completing the world’s largest ever metabolomic study is such a milestone:
UK Biobank has released the final set of data on nearly 250 metabolites – the molecules in our blood produced by our bodies as we go about our lives – in half a million volunteers.
Inside the world’s largest metabolomics study webinar
We hosted a webinar exploring the full NMR metabolomics dataset.

The session covered how the data were generated, what is available to researchers and how these measures are already supporting research into ageing, cardiometabolic disease, and risk prediction.
It also included practical guidance on accessing and analysing the data through the UKB-RAP.
Brain, heart and body images on 100,000 participants
New images from the world’s largest imaging project have now been uploaded to the UKB-RAP.
Additions include:

- 55,000 3D models of the pumping heart, providing personalised digital replicas to study cardiac health.
- Precise bone density measures, along with information on leg fat and hip shape, for an additional 30,000 participants, allowing researchers to delve into how genetics and lifestyle impact bone health and body composition.
- Data on how the brain structure changes over time, unlocking insights into brain ageing and neurodegenerative diseases like Alzheimer’s.
UK Biobank’s collection of whole-body MRI scans from 100,000 individuals is unmatched in scale and quality. These new imaging data are presented in a way which opens doors for researchers without traditional imaging expertise to integrate them into innovative studies and discoveries. I’m excited to see how this latest batch of data will fuel groundbreaking research into the ways our organs change as we age or develop disease.
Associate Professor Adam Lewandowski, Deputy Chief Scientist, UK Biobank
Social interactions and focus questionnaire

The UK Biobank social interactions and focus questionnaire provides a unique opportunity to examine autistic and ADHD traits in a large population of older adults. Responses from over 160,000 participants are now available to approved researchers on the UKB-RAP.
Research using these data has the potential to improve our understanding of neurodiversity and how people with neurodivergent traits can be better diagnosed and supported.
Drawing on our discussions with the UK Biobank Participant Advisory Group and topic experts, we encourage researchers to consider involving members of the neurodivergent community in their research to help them understand the social and societal implications of their findings.
UK Biobank participant Jane hopes this data will benefit autistic people.
Autism, historically, has been about young children, young boys in particular. I was diagnosed very late in life, and one aspect that clearly needs a lot of research is the area of comorbidity in autistic adults.
Jane, UK Biobank participant
For general guidance on the design, conduct, and reporting of neurodiversity research which may be helpful for researchers who are new to this field, take a look on at our online data browser Showcase.
Genetic information on early blood cells
Clonal haematopoiesis of indeterminate potential (CHIP) data looks at the genetic changes present in our blood cells as we get older.
CHIP can be an early indicator of disease, in particular blood cancers like multiple myeloma and cardiovascular disease, but these links aren’t fully understood yet.
Clonal haematopoiesis of indeterminate potential (CHIP) data for all 500,000 UK Biobank volunteers offer a unique opportunity to uncover connections between specific genetic changes in early blood cells and a wide range of conditions – far beyond heart disease and cancer. Without these data, many of these links could remain unknown.
Dr George Foody, Senior Bioinformatician, UK Biobank

Updated images of the retina
Retinal measurements, previously limited to use by specialists, are now available via UK Biobank.
Access to these highly detailed descriptions of eye health will help to connect the dots between patterns in the eye and wider disease risk.
And much more
Other updates include:
- More responses to our digestive health and experience of pain questionnaires.
- New genomic ancestry grouping data to promote increased diversity in studies.
- Updated healthcare records.
A full summary of the new and updated data available can be found on our Researcher Community, including links to our online data browser Showcase.
This data release is the second of this year, following an update in March 2025.
For participants interested in contributing further to UK Biobank, take a look at online questionnaires currently available to complete to help researchers find new insights into a range of health conditions.
Explore more
The answers from an in-depth survey on sleep behaviour, quality and disorders are now available to UK Biobank approved researchers.
Fill out our online questionnaires to help us build on our existing data with new insights into your health.
Our unique biomedical database is the largest, most detailed and most widely accessible of its kind.
Learn more about the researchers around the world who use UK Biobank data to make scientific discoveries that improve public health.